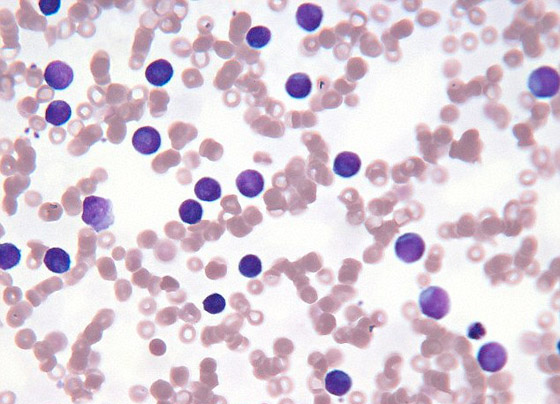

ظل فريق من الباحثين فى كندا والدنمارك سنوات طويلة يكثفون جهودهم من أجل التوصل إلى مصل جديد لوقاية السيدات الحوامل من الإصابة بالملاريا، حتى توصلوا بالصدفة إلى اكتشاف مثير للغاية، حيث ثبت أن العلاج الذى يقومون بتطويره يعالج 90% من أنواع السرطانات.
وسلط الباحثون المزيد من التفاصيل على هذا الاكتشاف المثير، مشيرين إلى أن أحد الكربوهيدرات الموجودة بمشيمة السيدات الحوامل ويستخدمها طفيل الملاريا للالتصاق بها وإصابتها، هو ذاته الذى يُستخدم بواسطة الخلايا السرطانية. وطور الباحثون بروتين يستخدمه طفيل الملاريا للالتصاق بالمشيمة وذلك بالاعتماد على الكربوهيدرات، وأضافوا إليه مادة سمية، بحيث يقتل طفيل الملاريا.

وأوضح الباحثون أن التجارب المعملية أثبتت أن البروتين المطور والمادة السمية يمكن استخدامهما لمكافحة السرطان، حيث ثبت أنهما يتوجهان أولاً إلى الخلايا السرطانية قبل أن تهاجم الخلايا المصابة بالملاريا، وبالتالى يمكن استغلال ذلك للقضاء على الأورام. المثير أن هذا الابتكار العلاجى يتمتع بفاعلية ضد 90% من أنواع السرطان منها أورام المخ وسرطان الدم اللوكيميا وسرطان البروساتا وسرطان العظام والأورام الليمفاوية. ويؤكد الباحثون أن هذه النتائج الرائعة ستمهد الطريق من أجل التوصل إلى علاج جديد للسرطان، ومن المقرر أن تبدأ التجارب الإكلينيكية على الكثير من المرضى خلال الأربع سنوات القادمة.